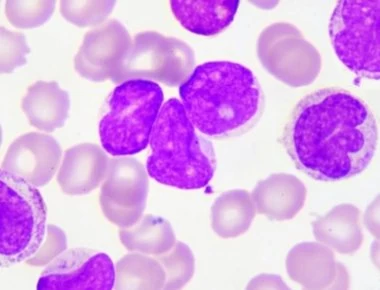
Λευχαιμία- λέμφωμα: Ποιες είναι οι διαφορές- Τι πρέπει να ξέρετε

ΥΓΕΙΑ
-

Ιθάκη: Άρρωστοι μαθητές και δάσκαλοι- Κλειστά σχολεία λόγω έξαρσης ιώσεων
Κλειστά είναι τα νηπιαγωγεία και τα δημοτικά σχολεία στην Ιθάκη λόγω της έξαρσης των εποχιακών ιώσεων και του μεγάλου αριθμού απουσιών μαθητών και εκπαιδευτικών από τα σχολεία λόγω ασθένειας.Με έκτακτ...
Read More » -

Mε αυτά τα κόλπα θα χάσεις μέχρι και 2 κιλά την εβδομάδα
Το να χάνεις βάρος γρήγορα είναι σχεδόν πάντα ανθυγιεινό. Η απώλεια λίπους είναι αυτή που αλλάζει τη δομή του σώματός σου.Ακόμη και αν καταφέρεις να πετύχεις τον στόχο σου ωστόσο με τη γρήγορη δίαιτα,...
Read More » -

Με αυτόν τον τρόπο θα ανακουφιστείτε από τα αέρια στο στομάχι
Οι κοιλιακοί πόνοι από συσσώρευση φυσικών αερίων στο εντερικό σύστημα (μετεωρισμός ή, πιο απλά, τυμπανισμός) είναι ένα πολύ σύνηθες πρόβλημα σε πολλούς ανθρώπους. Οι πόνοι από τα αέρια στο στομάχι συν...
Read More » -

Μουρουνέλαιο: Τι προσφέρει και ποιες παθήσεις καταπολεμάει
Το μουρουνέλαιο, όπως υποδηλώνει και το όνομά του, είναι το αιθέριο έλαιο που εξάγεται από το συκώτι του ψαριού “μουρούνα” ή “γάδου” (Gadus morhua).Το μουρουνέλαιο συνήθως λαμβάνεται ως συμπλήρωμα δια...
Read More » -

Αυτά είναι τα 5 αντικείμενα που αποτελούν κίνδυνο για την υγεία σας- Υπάρχουν σε κάθε σπίτι
Όταν μιλάμε για τα βήματα που πρέπει να ακολουθήσει κανείς για να είναι πιο υγιής, συχνά κάνουμε αναφορά στην αγορά νέων πραγμάτων: ρούχα προπόνησης, όργανα γυμναστικής, υλικά για υγιεινές συνταγές κα...
Read More » -
Λευχαιμία- λέμφωμα: Ποιες είναι οι διαφορές- Τι πρέπει να ξέρετε
Σε αυτό το άρθρο, εξετάζουμε διεξοδικά τις ομοιότητες και τις διαφορές μεταξύ της λευχαιμίας και του λεμφώματος.Αν και υπάρχουν κάποιες ομοιότητες ανάμεσα στην λευχαιμία και το λέμφωμα, εντούτοις οι α...
Read More » -

ΠΟΕΔΗΝ: Εμπόλεμη ζώνη στο νοσοκομείο της Νίκαιας- Ράντζα μέχρι τις σκάλες
«Το Νοσοκομείο της Νίκαιας ξεπέρασε τις κόκκινες γραμμές για τους ασθενείς. Χθες Δευτέρα που εφημέρευε έως σήμερα το πρωί της Τρίτης 22/01/2019 η κατάσταση ήταν ανυπόφορη για τους ασθενείς, συνοδούς κ...
Read More » -

Οι ανοσοθεραπείες του καρκίνου πιθανόν συνδέονται με τις ρευματικές παθήσεις
Σε μελέτη που καταγράφεται στο Medline εξετάστηκαν οι μυοσκελετικές και ρευματικές παθήσεις που προκλήθηκαν από αναστολείς ανοσολογικών σημείων ελέγχου.Η θεραπεία αναστολέων του σημείου ελέγχου είναι ...
Read More » -

Η Ελλάδα γερνάει! Σημαντική μείωση γεννήσεων και αύξηση θανάτων
«Σβήνει» η Ελλάδα λόγω υπογεννητικότητας και πώς θα επέλθει η δημογραφική ισορροπία; Επιδεινώθηκε σε σοβαρό βαθμό η μείωση των γεννήσεων στην Ελλάδα, απόρροια της οικονομικής κρίσης και της υπαγωγής τ...
Read More » -

Αιμοχρωμάτωση: Η «σιωπηλή» ασθένεια που καταστρέφει το ήπαρ
Μια ασθένεια που την αντιλαμβάνεται ο ασθενείς όταν πλέον έχει προχωρήσει αρκετά. Ένας από τους μεγαλύτερους κινδύνους του ήπατος. Η κληρονομική αιμοχρωμάτωση είναι μια από τις πιο κοι...
Read More »
